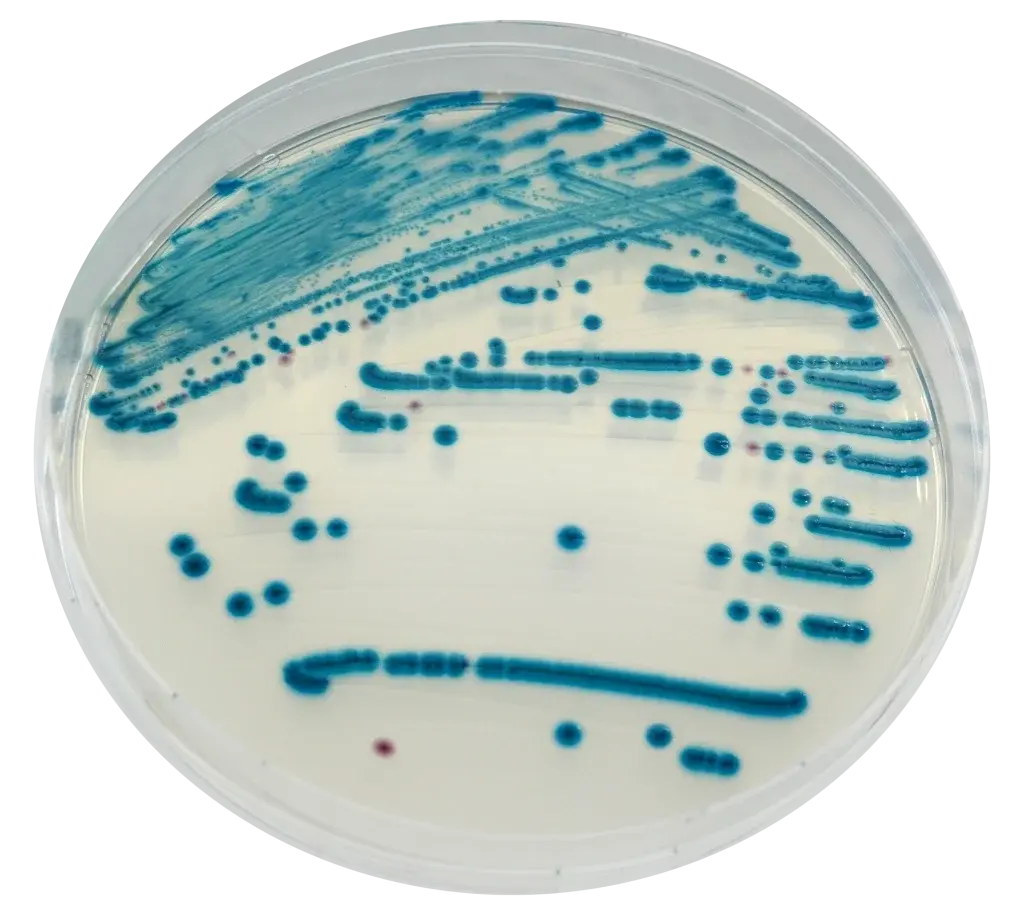
Chromagar Stec 10 Adet

Chromagar Stec 10 Adet
1.334,24 TL
*136,92 TL den başlayan taksitlerle!
CHROMagar STEC, mikrobiyoloji laboratuvarlarında kullanılmak üzere tasarlanmış özel bir besiyeridir. Bu ürün, CHROMagar markasının güvenilirliği ve kalitesi ile bilinmektedir. CHROMagar STEC, Shiga toksin üreten E. coli (STEC) türlerini saptamak için ideal bir seçenektir.
Ürün Özellikleri:
- STEC türlerini hassas bir şekilde belirlemek için özel olarak formüle edilmiştir.
- Mavi renk değişimi ile kolayca STEC tespiti yapılmasını sağlar.
- Özel besiyeri formülü sayesinde yüksek doğruluk ve güvenilir sonuçlar elde edilir.
- Kolay kullanımı sayesinde laboratuvar verimliliğini arttırır.
- Her bir pakette 10 adet CHROMagar STEC bulunmaktadır.
Mikrobiyoloji laboratuvarlarında güvenilir sonuçlar elde etmek ve STEC tespiti için CHROMagar STEC tercih edebilirsiniz. Sağladığı kolay kullanım ve yüksek doğruluk ile mikrobiyoloji çalışmalarınızı daha verimli hale getirecektir.
Bu ürüne ilk yorumu siz yapın!